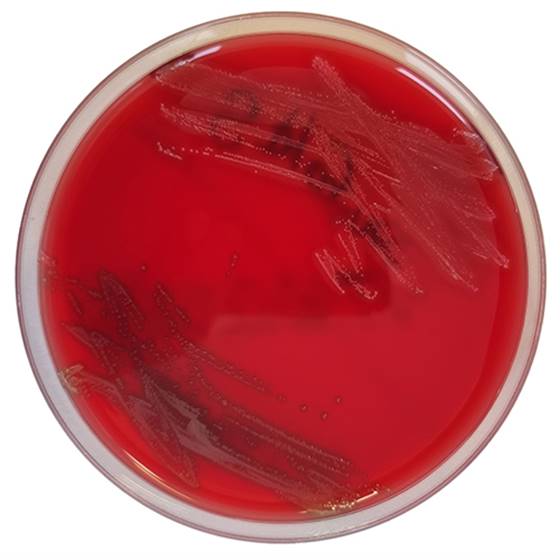

Über das Produkt
Fertigplatten zur Empfindlichkeitsprüfung von Haemophilus influenzae, Streptococcus spp. und anderen anspruchsvollen Mikroorganismen.
Produkte
Mikrobiologie
Fertigplatten
Mueller-Hinton-II-Agar mit 5 % Pferdeblut + 20 mg/l NAD EUCAST, Fertigplatten
Mueller-Hinton-II-Agar mit 5 % Pferdeblut + 20 mg/l NAD EUCAST, Fertigplatten
Fertigplatten zur Empfindlichkeitsprüfung von Haemophilus influenzae, Streptococcus spp. und anderen anspruchsvollen Mikroorganismen.